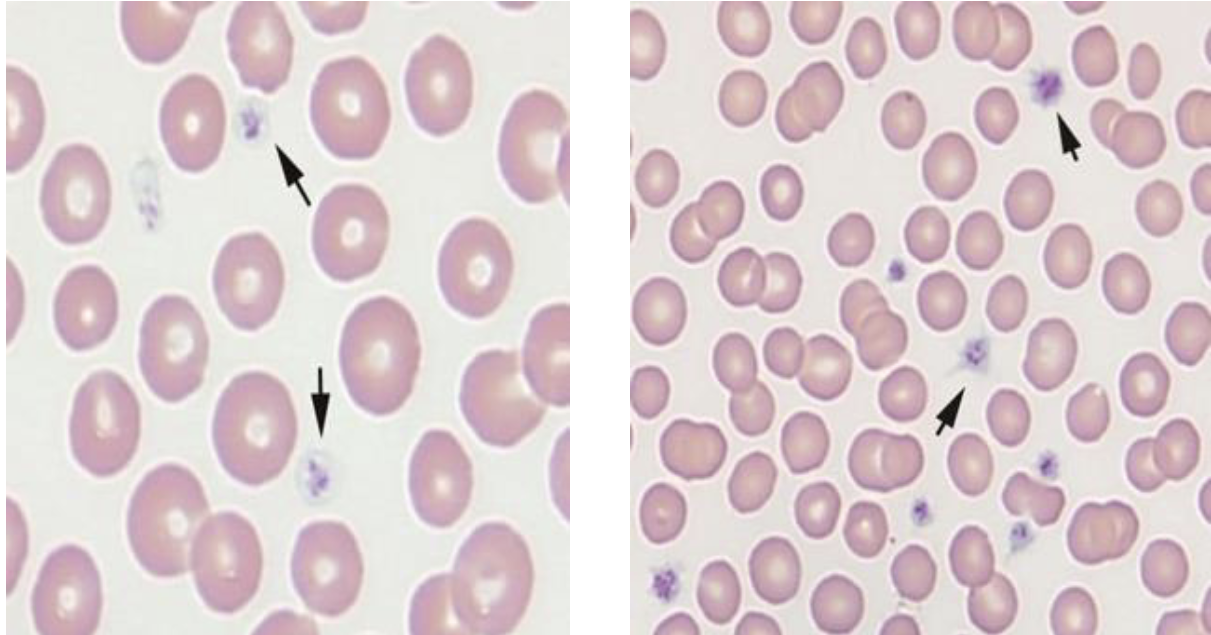
<p>Platelets </p>
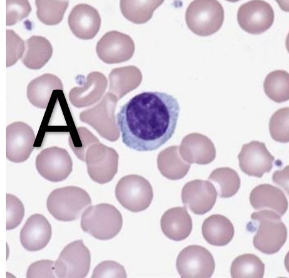
<p>What type of cell is this?</p>
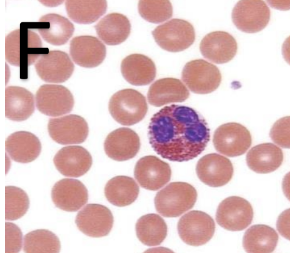
<p>What type of cell is this?</p>
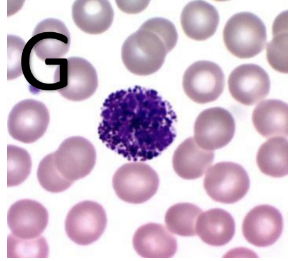
<p>What type of cell is this?</p>
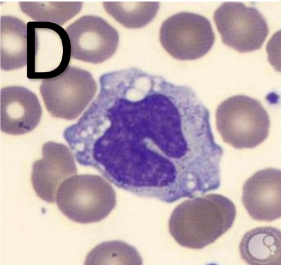
<p>monocyte </p>
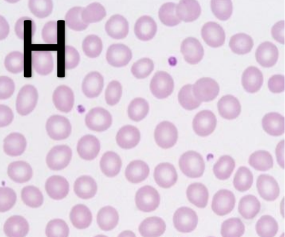
<p>What type of cell is this?</p>
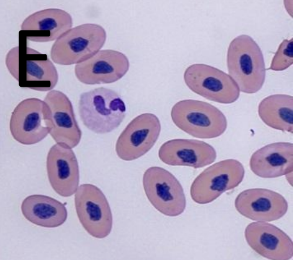
<p>What type of cell is this?</p>
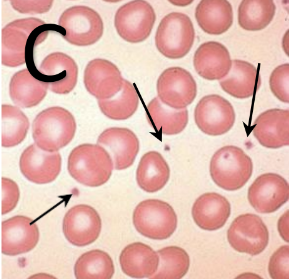
<p>What type of cell is this?</p>
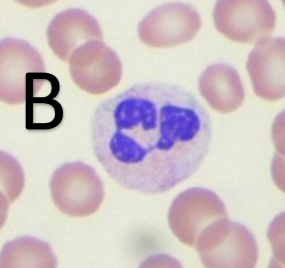
<p>What type of cell is this?</p>

White Blood Cells (Leukocytes)
1/36
There's no tags or description
Looks like no tags are added yet.
Name | Mastery | Learn | Test | Matching | Spaced | Call with Kai |
|---|
No analytics yet
Send a link to your students to track their progress
37 Terms
What are granulocytes?
any WBC with distinct cytoplasm granules
What cells are classified as granulocytes?
neutrophil, eosinophil, basophil
What are agranulocytes?
WBC that has no visible cytoplasmic granules
What cells are classified as Agranulocytes?
Lymphocytes and Monocytes
What species does this neutrophil belong to?
Canine

What species does this neutrophil belong to?
Feline

What species doe this neutrophil belong to?
Equine

What species does this neutrophil belong to?
Bovine

What type of neutrophil is this?
Band neutrophil


What species does this eosinophil belong to?
Canine

What species does this eosinophil belong to?
Feline
What species does this eosinophil belong to?
Equine

What species does this eosinophil belong to?
Bovine

What species does this eosinophil belong to?
Greyhound

What species does this basophil belong to?
Canine

What species does this basophil belong to?
Feline

What species does this basophil belong to?
Equine

What species does this basophil belong to?
Bovine


What species does this monocyte belong to?
Canine

What species does this monocyte belong to?
Feline
What species does this monocyte belong to?
Equine


What species does this monocyte belong to?
Bovine
What species does this lymphocyte belong to?
Canine


What species does this lymphocyte belong to?
Feline

What species does this lymphocyte belong to?
Equine
What species does this lymphocyte belong to?
Bovine

What type of lymphocyte is this?
Reactive

What type of lymphocyte is this?
Granular

What type of cell is this?
Platelets

What type of cell is this?
lymphocyte
What type of cell is this?
eosinophil
What type of cell is this?
basophil
What type of cell is this?
monocyte

What type of cell is this?
erythrocyte
What type of cell is this?
heterophil (birds)
What type of cell is this?
thrombocyte
What type of cell is this?
neutrophil (segmented)